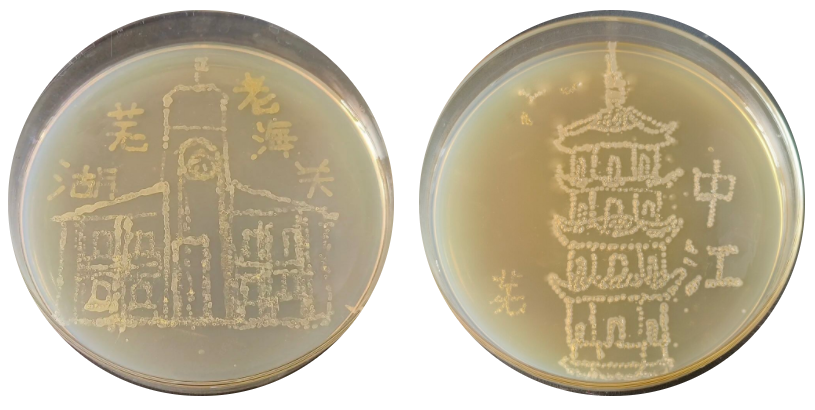

从王希孟的《千里江山图》到芜湖的中江塔、老海关等美景,再到附中120周年校庆、校徽等元素,这些内容如今被安师大附中一群高二学生以一种意想不到的独特方式——“微生物绘画”重新呈现。
大江资讯记者日前在安师大附中的生物实验室里看到,圆形的培养皿就像是一个天然画框,框里《千里江山图》(局部)、中江塔、鸠顶泽瑞等形象都以线条形式表现出来,形象生动,意趣盎然。
《千里江山图》,左为微生物绘画,右为原画

上为《只此青绿》图,下为京剧刀马旦和迎客松

左为芜湖老海关,右为中江塔

左为鸠顶泽瑞,右为“芜”字样

左为三只松鼠,右为镜湖公园


课题组负责人顾涛老师告诉记者,这些颜色斑斓、粗细不一的线条就是各种微生物菌落生长的印迹。培养皿中的各种颜色来自不同菌落天然色彩:
顾涛介绍说,在课本里,微生物的培养技术以及应用只涉及简单微生物的培养技术和无菌操作。而 “微生物作画”项目却由此延伸,以S(科学)为主线,在方案中将E(工程学)、T(技术)、A(艺术)和M(数学)有效地结合起来,探究中华传统文化、芜湖本土文化、附中校园文化与微生物作画结合,进行微生物作画,充分体现了跨学科的理念,培养学生的核心素养和创新能力,是高中生物很有代表性的一次项目式学习案例。“看到三只松鼠、中江塔等芜湖美景从我手中以这种方式诞生,真的很有成就感。”参加项目的高二学生利心蕊在接受采访时说,课本里的实验室操作言简意赅,然而实际并不简单。首先创意上叠加了文创元素,操作时又会遇到各种问题,包括培养基的配置、消毒灭菌,微生物接种、作画、培养……每个环节都不能出错,才能实现最后的效果。同学们说,为了完成这个项目,花了6个月,耗费了无数个周末和晚上,经历多次失败,不断实验和改进,所有人一起努力,最终才呈现出了颇有美感的微生物画作。通过这个项目,他们不仅锻炼了动手动脑能力,学会了从另一个角度观察理解世界,而且还收获了一段珍贵的学习经历和成长记忆。据了解,“微生物绘画”是芜湖市教育高层次人才第二批分层培养项目——“基于STEAM教育的高中生物项目式学习课程的开发与研究”课程内容之一。在附中,该项目由课题组负责人顾涛及成员方大伟、朱飞虎带领高二年级近200名学生经过近半年的课程实践共同完成。不着一丝笔墨,绘尽世间万种风情
不寻常的画材,创造震撼人心的美
这样特别的画,你喜欢吗?